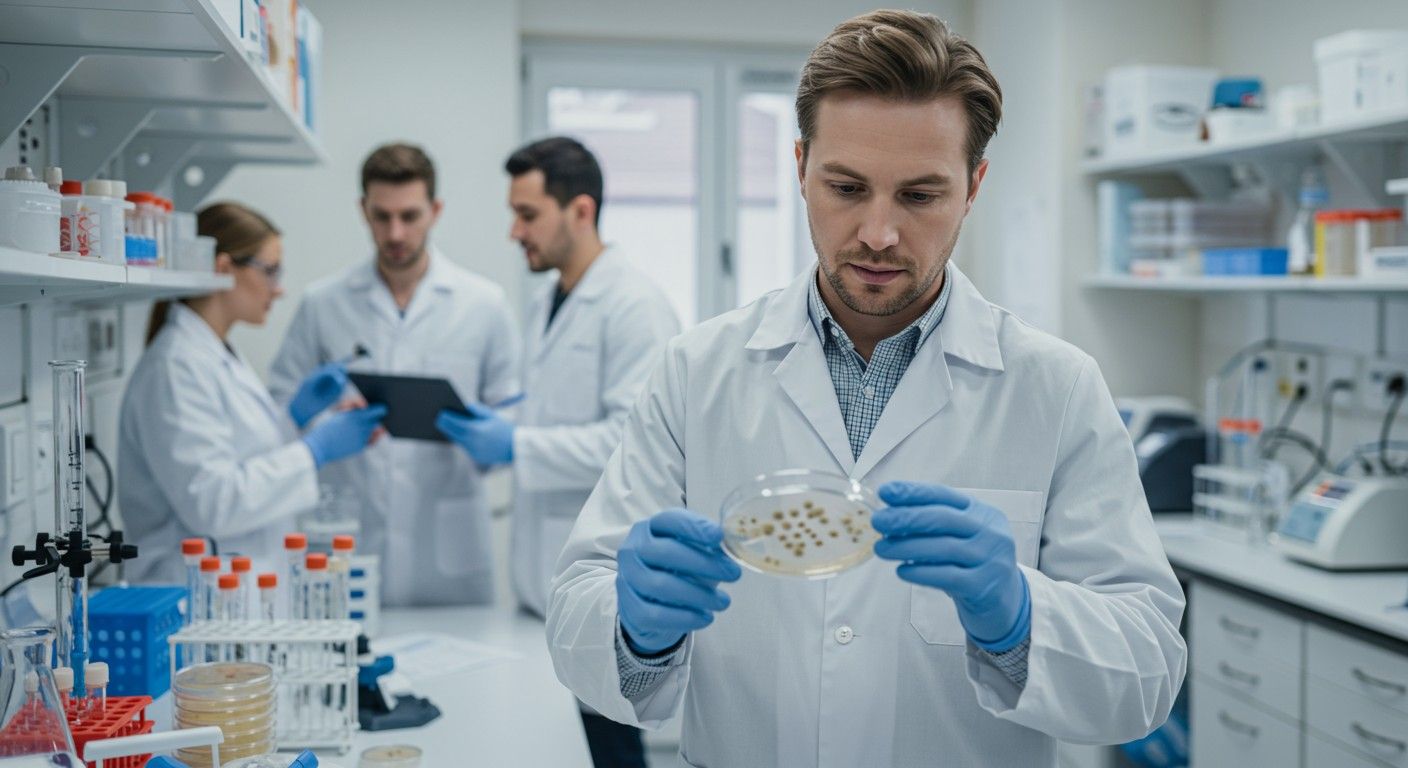
A fungisztatikus szerek gátolják a gombák szaporodását.

A biológiában, különösen az orvostudományban, a mezőgazdaságban és az élelmiszeriparban, a gombák elleni védekezés kulcsfontosságú feladat. Ezek az eukarióta mikroorganizmusok rendkívül sokfélék, és számos területen okozhatnak problémát, a humán és állati fertőzésektől kezdve a növényi betegségeken át az élelmiszerek romlásáig. A gombaellenes stratégiák két fő megközelítésre épülnek: a fungicid és a fungisztatikus hatásra.
A fungisztatikus szerek olyan vegyületek, amelyek nem pusztítják el közvetlenül a gombákat, hanem gátolják azok növekedését és szaporodását. Ez a megkülönböztetés alapvető fontosságú a terápiás és védekezési stratégiák megválasztásában, mivel a fungisztatikus hatású anyagok gyakran kevésbé toxikusak a gazdaszervezetre nézve, és lehetővé teszik a szervezet saját immunrendszerének vagy a környezeti tényezőknek, hogy végül felszámolják a gombaállományt.
A fungisztatikus megközelítés széleskörűen alkalmazható, ahol a gombák teljes elpusztítása nem feltétlenül szükséges, vagy ahol a fungicid szerek toxicitása túlságosan magas lenne. Ez a módszer különösen releváns krónikus fertőzések kezelésében, megelőző célokra, vagy olyan rendszerekben, ahol a gombák jelenlétét csupán a kritikus szint alatt kell tartani.
A fungisztatikus és fungicid hatás közötti különbségek
A gombaellenes szerek hatásmechanizmusuk alapján két fő kategóriába sorolhatók: fungisztatikus és fungicid. A fungicid szerek célja a gombák elpusztítása, irreverzibilis károsodást okozva a sejtstruktúrában vagy a metabolikus folyamatokban. Ezzel szemben a fungisztatikus vegyületek csak ideiglenesen vagy reverzibilisen gátolják a gombák növekedését és szaporodását.
Ez a különbség jelentős következményekkel jár a klinikai gyakorlatban és más alkalmazási területeken. A fungicid szerek gyorsabb hatást eredményezhetnek, és gyakran előnyösebbek súlyos, életveszélyes fertőzések esetén, különösen immunhiányos betegeknél, ahol a gazdaszervezet immunválasza nem elegendő a fertőzés leküzdéséhez.
A fungisztatikus szerek alkalmazásakor a gombák növekedése leáll, de életképesek maradnak. Ez azt jelenti, hogy a kezelés abbahagyása után a gombák potenciálisan újra szaporodhatnak, ha a körülmények kedvezővé válnak. Ezért a fungisztatikus terápiák gyakran hosszabb időtartamúak, és a gazdaszervezet immunrendszerének vagy más védekező mechanizmusainak aktív közreműködésére támaszkodnak a fertőzés teljes felszámolásában.
A választás a két típus között számos tényezőtől függ, beleértve a gomba típusát, a fertőzés helyét és súlyosságát, a gazdaszervezet állapotát, valamint a szer lehetséges mellékhatásait. Bizonyos esetekben egy adott szer koncentrációja is meghatározhatja, hogy fungisztatikus vagy fungicid hatást fejt ki.
A fungisztatikus szerek kritikus szerepet játszanak a krónikus gombás fertőzések kezelésében, ahol a hosszú távú hatékonyság és a minimális mellékhatások prioritást élveznek a gombák azonnali elpusztításával szemben.
A gombák biológiai sokfélesége és a gombaellenes szerek szükségessége
A gombák rendkívül sokszínűek, több mint 100 000 ismert fajuk létezik, és becslések szerint akár 1,5 millió faj is élhet a Földön. Ezek az eukarióta szervezetek kulcsfontosságú szerepet játszanak az ökoszisztémákban lebontóként, szimbiontaként vagy parazitaként. Azonban számos gombafaj jelentős kihívást jelent az emberi egészség, az állattenyésztés, a növényvédelem és az élelmiszerbiztonság szempontjából.
Az emberi patogének közé tartoznak például a Candida fajok, amelyek opportunista fertőzéseket okoznak, vagy az Aspergillus és Cryptococcus fajok, amelyek súlyos, invazív betegségeket idézhetnek elő, különösen immunhiányos egyéneknél. A bőrfelületi gombás fertőzések, mint például a tinea pedis (lábgomba) vagy a tinea corporis (testi gombásodás), szintén gyakoriak és a mindennapi életminőséget rontó problémát jelentenek.
Az állatgyógyászatban is komoly gazdasági károkat okozhatnak a gombás megbetegedések, például a baromfi aspergillózisa vagy a szarvasmarhák dermatophytosisa. A növények esetében a gombás fertőzések, mint a lisztharmat, a rozsda vagy a peronoszpóra, hatalmas terméskiesést okozhatnak, veszélyeztetve az élelmiszerellátást.
Az élelmiszeriparban a penészgombák felelősek számos termék romlásáért, és toxinjaik (mikotoxinok) súlyos egészségügyi kockázatot jelenthetnek. Az építőiparban és a műemlékvédelemben is problémát jelentenek a nedves környezetben elszaporodó gombák, amelyek szerkezeti károkat és esztétikai romlást okoznak.
A gombák elleni védekezés bonyolultságát növeli az is, hogy eukarióta szervezetek lévén, sok alapvető sejtfunkciójuk hasonló a gazdaszervezetekéhez. Ez megnehezíti olyan szerek fejlesztését, amelyek szelektíven károsítják a gombát anélkül, hogy a gazdasejteket is károsítanák. Ezért van szükség olyan célzott, hatékony és biztonságos gombaellenes szerekre, amelyek minimalizálják a mellékhatásokat.
A fungisztatikus szerek hatásmechanizmusai molekuláris szinten
A fungisztatikus szerek sokféle molekuláris mechanizmuson keresztül fejtik ki hatásukat, gátolva a gombák növekedéséhez és szaporodásához elengedhetetlen folyamatokat. Ezek a mechanizmusok általában a gombasejt egyedi struktúráit vagy metabolikus útvonalait célozzák meg, amelyek eltérnek a gazdaszervezet sejtjeitől, ezáltal biztosítva a szelektivitást.
Az egyik leggyakoribb célpont a gombasejt membránjának integritása és funkciója. Az azolok, mint például a fluconazol vagy az itraconazol, gátolják az ergosterol bioszintézisét. Az ergosterol a gombasejt membránjának kulcsfontosságú lipid komponense, amely funkcionálisan megfelel az állati sejtek koleszterinjének. Az ergosterol szintézis gátlásával a membrán permeabilitása megnő, ami a sejt normális működésének zavarához és végül a növekedés leállásához vezet.
Egy másik fontos célpont a gombasejt falának szintézise. A gombasejt fal egy merev külső réteg, amely alapvető a sejt integritásához és ozmotikus stabilitásához. Az echinocandinok, mint például a caspofungin, gátolják a β-(1,3)-D-glukán szintézist, amely a gombasejt falának egyik fő alkotóeleme. Bár az echinocandinokat gyakran fungicidnek tekintik bizonyos gombák ellen, más fajok esetében elsősorban fungisztatikus hatást fejtenek ki, gyengítve a sejtfalat és gátolva a növekedést.
A nukleinsav-szintézis gátlása is hatékony fungisztatikus stratégia. A flucytozin egy pirimidin analóg, amelyet a gombasejtek felvesznek, majd 5-fluorouracillá metabolizálnak. Ez a metabolit beépül a gombák RNS-ébe, gátolva a fehérjeszintézist, és zavarja a DNS-szintézist is. Mivel a humán sejtek nem rendelkeznek azokkal az enzimekkel, amelyek a flucytozint átalakítanák, a szer szelektivitása viszonylag magas.
Vannak olyan szerek is, amelyek a mikrotubulusok működését célozzák. A griseofulvin például beavatkozik a gombasejtek mikrotubulusainak képződésébe, ami gátolja a mitózist és a sejtek osztódását. Ez a mechanizmus különösen hatékony a dermatophytonok (bőrgombák) ellen, mivel meggátolja a hifák növekedését és terjedését.
Összességében a fungisztatikus szerek a gombasejt számos létfontosságú folyamatát befolyásolhatják, beleértve a membrán integritását, a sejtfal felépítését, a genetikai anyag szintézisét és a sejtosztódást. Az ezen mechanizmusok sokfélesége lehetővé teszi a célzott terápiák kidolgozását, figyelembe véve a gomba típusát és a gazdaszervezet sajátosságait.
A fungisztatikus szerek finomhangolt beavatkozást jelentenek a gombák életciklusába, megállítva a növekedést anélkül, hogy azonnal elpusztítanák őket, ami különösen előnyös hosszú távú kezelések során.
Fungisztatikus szerek a humán gyógyászatban
A humán gyógyászatban a fungisztatikus szerek széles körben alkalmazottak a gombás fertőzések kezelésére, a felületes bőrgombáktól egészen a szisztémás, invazív mycosisokig. A választás a fungisztatikus és fungicid terápia között gyakran a fertőzés súlyosságától, a kórokozó gomba típusától és a beteg immunstátuszától függ.
A azolok, mint például a fluconazol, itraconazol és voriconazol, a leggyakrabban használt fungisztatikus szerek közé tartoznak. Ezek az ergosterol bioszintézisének gátlásával fejtik ki hatásukat, destabilizálva a gombasejt membránját. A fluconazol kiválóan alkalmazható nyálkahártya- és szisztémás candidiasis, valamint cryptococcosis kezelésére. Az itraconazol szélesebb spektrumú, és hatékony aspergillosis, hisztoplazmózis és onychomycosis (körömgomba) ellen.
A griseofulvin egy régebbi fungisztatikus szer, amelyet elsősorban dermatophyton fertőzések, például tinea capitis (hajlati gombásodás) és tinea corporis kezelésére használnak. Hatásmechanizmusa a gombasejt mikrotubulusainak gátlásán alapul, megakadályozva a sejtosztódást. Mivel a gyógyszer beépül a keratinba, hatékonyan védi az újonnan növő hajat, bőrt és körmöket a fertőzéstől.
A flucytozin (5-fluorocytozin) egy pirimidin analóg, amelyet gyakran kombinálnak más gombaellenes szerekkel, például amphotericin B-vel, súlyos szisztémás fertőzések, mint a cryptococcosis vagy a candidiasis kezelésére. Monoterápiában rezisztencia kialakulása miatt ritkán alkalmazzák. A gombasejtekbe bejutva 5-fluorouracillá alakul, ami zavarja a DNS és RNS szintézist.
A fungisztatikus szerek előnyei közé tartozik a gyakran alacsonyabb toxicitás a gazdaszervezetre nézve, mint a fungicid vegyületek esetében, valamint az, hogy lehetővé teszik a szervezet immunrendszerének bekapcsolódását a fertőzés leküzdésébe. Ez különösen fontos enyhébb vagy krónikus fertőzések esetén, ahol a hosszú távú kezelés szükséges lehet.
Hátrányuk, hogy a kezelés abbahagyása után a fertőzés visszatérhet, ha a gombák nem pusztultak el teljesen, vagy ha a gazdaszervezet immunválasza nem elegendő. Ezért kulcsfontosságú a terápia teljes időtartamának betartása és a beteg állapotának szoros monitorozása.
Klinikai alkalmazások és kihívások
A felületes gombás fertőzések, mint a bőr- és körömgombák, gyakran kezelhetők helyi fungisztatikus szerekkel vagy szájon át szedhető azolokkal. Ezek a gyógyszerek viszonylag biztonságosak és hatékonyak, de hosszú távú alkalmazást igényelhetnek, különösen a körömgomba esetében, ahol a kezelés akár 6-12 hónapig is eltarthat.
Szisztémás fertőzések esetén a fungisztatikus szerek gyakran adjuvánsként, vagy fenntartó terápiaként szolgálnak az akut fázis után. Például az invazív aspergillosis kezelésében a voriconazol fungisztatikus hatása döntő lehet a hosszú távú kimenetel szempontjából. Azonban súlyos, életveszélyes fertőzések esetén az elsődleges terápia általában fungicid szerekkel, például amphotericin B-vel történik.
A fungisztatikus szerek alkalmazásakor felmerülő kihívások közé tartozik a gyógyszerkölcsönhatások lehetősége, különösen az azolok esetében, amelyek a máj citokróm P450 enzimrendszerét befolyásolhatják. Emellett a gombaellenes rezisztencia kialakulása is egyre növekvő probléma, ami szükségessé teszi az új szerek fejlesztését és a meglévő terápiák optimalizálását.
A betegek adherenciája, vagyis a kezelési protokoll betartása is kritikus. Mivel a fungisztatikus kezelések hosszúak lehetnek, a betegek hajlamosak idő előtt abbahagyni a gyógyszer szedését, ami a fertőzés kiújulásához és rezisztencia kialakulásához vezethet. Az orvos és a beteg közötti kommunikáció, valamint a betegoktatás ezért elengedhetetlen a sikeres terápia szempontjából.
Fungisztatikus szerek az állatgyógyászatban
Az állatgyógyászatban a fungisztatikus szerek hasonlóan fontos szerepet töltenek be, mint a humán orvoslásban. A háziállatok, haszonállatok és egzotikus állatok is szenvedhetnek gombás fertőzésektől, amelyek súlyos betegségeket, gazdasági veszteségeket és akár halált is okozhatnak.
A kutyák és macskák esetében a dermatophytosis (gyűrűsféreg), amelyet leggyakrabban a Microsporum canis okoz, az egyik leggyakoribb gombás bőrbetegség. Ennek kezelésére gyakran alkalmaznak szájon át adagolt fungisztatikus szereket, mint például az itraconazolt vagy a griseofulvint. Ezek a szerek bejutnak a szőrtüszőkbe és a bőrbe, gátolva a gombák növekedését, miközben a fertőzött szőr kihullik és új, egészséges szőr nő a helyére.
A szisztémás gombás fertőzések, mint a cryptococcosis (különösen macskáknál) vagy az aspergillosis (kutya, madarak), szintén igényelnek gombaellenes terápiát. Ezekben az esetekben az azolok, mint a fluconazol vagy az itraconazol, gyakran az elsődleges választás, mivel jól tolerálhatók és hatékonyan gátolják a gombák növekedését a szervezetben.
A lovaknál a gombás fertőzések, például a Malassezia dermatitis vagy az aspergillosis, szintén előfordulhatnak, és kezelésük során szintén fungisztatikus vegyületeket alkalmaznak. Az antibiotikumok túlzott használata néha hajlamosíthatja az állatokat gombás felülfertőzésre, különösen a bélflóra egyensúlyának felborulása miatt.
A haszonállatok, például baromfi vagy szarvasmarha, esetében a gombás fertőzések, mint a baromfi aspergillózisa vagy a szarvasmarhák mycoticus abortusa, jelentős gazdasági károkat okozhatnak. Itt a megelőzés és a korai beavatkozás kulcsfontosságú. A takarmányba kevert fungisztatikus adalékanyagok segíthetnek megakadályozni a penészgombák elszaporodását és a mikotoxinok termelődését, ezáltal javítva az állatok egészségét és termelékenységét.
Adagolás és kezelési sajátosságok
Az állatgyógyászati fungisztatikus kezelések adagolása és időtartama az állatfajtól, testtömegétől, a fertőzés típusától és súlyosságától függ. Fontos a pontos diagnózis és a megfelelő gyógyszer kiválasztása, figyelembe véve az állat specifikus metabolizmusát és a lehetséges mellékhatásokat.
Például, a macskák mája eltérően metabolizálja az egyes gyógyszereket, ezért bizonyos azolok, mint a ketoconazol, toxikusabbak lehetnek számukra, mint a kutyáknak. Az itraconazolt gyakran mikroemulziós formában adják be, ami javítja a felszívódását és csökkenti a mellékhatásokat.
A hosszú távú kezelés, amely a fungisztatikus szerek esetében gyakran szükséges, kihívásokat jelenthet az állattartók számára. Fontos a gyógyszeres terápia pontos betartása, még akkor is, ha az állat tünetei már javulnak, hogy elkerülhető legyen a fertőzés kiújulása és a rezisztencia kialakulása.
Az állatgyógyászatban is egyre nagyobb problémát jelent a gombaellenes rezisztencia, különösen a krónikus vagy ismétlődő fertőzések esetén. Ezért a kezelő állatorvosnak folyamatosan figyelemmel kell kísérnie a legújabb kutatási eredményeket és a rezisztencia mintázatokat a hatékony terápia biztosítása érdekében.
Fungisztatikus szerek a növényvédelemben és mezőgazdaságban
A növényvédelemben és a mezőgazdaságban a gombás betegségek jelentős terméskiesést okozhatnak, veszélyeztetve az élelmiszerbiztonságot és a gazdaságok jövedelmezőségét. A fungisztatikus szerek, azaz a fungisztatikus hatású fungicidek, kulcsfontosságú eszközt jelentenek ezen problémák kezelésében, mivel gátolják a kórokozó gombák növekedését és terjedését a növényeken.
Számos fungisztatikus hatóanyagot alkalmaznak a növényvédelemben, amelyek különböző mechanizmusokon keresztül fejtik ki hatásukat. Az azol típusú fungicidek, mint például a tebuconazol vagy a propiconazol, gátolják az ergosterol bioszintézisét a gombasejt membránjában, hasonlóan az orvosi alkalmazású azolokhoz. Ezek széles spektrumúak és hatékonyak számos gabonaféle, gyümölcs és zöldség gombás betegsége ellen, mint például a lisztharmat, a rozsda vagy a szeptóriás levélfoltosság.
A strobilurin típusú fungicidek, mint az azoxistrobin vagy a piraclostrobin, a gombák légzését gátolják a mitokondriumokban, meggátolva az ATP termelést. Ez a mechanizmus rendkívül hatékony a gombák növekedésének és spóraképzésének megállításában. Széles körben használják őket gabonafélék, kukorica, rizs, gyümölcsök és zöldségek védelmére különböző kórokozók, például peronoszpóra és alternária ellen.
A karboxamid típusú fungicidek, mint a boscalid, a szukcinát-dehidrogenáz (SDH) enzimet gátolják, amely kulcsszerepet játszik a gombák légzési láncában. Ezek a szerek hatékonyak a penészgombák, a rozsdák és a szklerotíniás betegségek ellen, és gyakran alkalmazzák őket repcében, napraforgóban és zöldségekben.
A fungisztatikus fungicidek előnye, hogy gyakran szisztémásak, azaz a növény felveszi őket, és a nedvszállító rendszeren keresztül eljutnak a növény minden részébe, így védelmet nyújtanak a még nem fertőzött részeknek is. Ez lehetővé teszi a belső védekezést és a hosszú távú hatást.
Rezistencia kezelése és környezeti hatások
A növényvédelemben a gombaellenes rezisztencia kialakulása komoly aggodalmat jelent. A gombák gyorsan képesek rezisztenciát fejleszteni a gyakran használt fungisztatikus szerekkel szemben. Ennek megelőzése érdekében a gazdálkodók rotálják a különböző hatásmechanizmusú fungicideket, és kombinált készítményeket alkalmaznak. A rezisztencia-menedzsment stratégiák kulcsfontosságúak a fungisztatikus szerek hosszú távú hatékonyságának megőrzésében.
A környezeti hatások is fontos szempontot jelentenek. A fungisztatikus fungicidek alkalmazásakor figyelembe kell venni a méhek és más hasznos rovarok védelmét, a vízi élővilágra gyakorolt hatásukat, valamint a talajban való lebomlásukat. A modern fungisztatikus szerek fejlesztése során nagy hangsúlyt fektetnek a környezetbarát tulajdonságokra és a célzottabb hatásra.
A fungisztatikus szerek alkalmazása hozzájárul a termés minőségének és mennyiségének megőrzéséhez, csökkenti a mikotoxinok kockázatát az élelmiszerekben, és biztosítja a fenntartható mezőgazdasági termelést. Azonban a felelős és integrált növényvédelmi stratégiák elengedhetetlenek a hatóanyagok hatékonyságának megőrzéséhez és a környezeti terhelés minimalizálásához.
Fungisztatikus szerek az élelmiszeriparban és tartósításban
Az élelmiszeriparban a fungisztatikus szerek létfontosságú szerepet játszanak az élelmiszerek minőségének megőrzésében és eltarthatóságának növelésében. A penészgombák és élesztőgombák az élelmiszerek egyik leggyakoribb romlását okozó mikroorganizmusai, amelyek nemcsak az élelmiszer élvezeti értékét csökkentik, hanem mikotoxinok termelésével súlyos egészségügyi kockázatot is jelenthetnek.
A élelmiszer-tartósítószerek jelentős része fungisztatikus hatású. Ezek a vegyületek gátolják a gombák növekedését és szaporodását, ezáltal lassítva a romlási folyamatokat. Néhány gyakran használt példa:
- Propionátok (pl. kalcium-propionát, nátrium-propionát): Ezeket elsősorban pékárukban, például kenyérben és süteményekben használják a penészesedés megelőzésére. A propionátok a gombasejtek metabolizmusába avatkoznak be, gátolva azok energiatermelését.
- Szorbátok (pl. kálium-szorbát): Széles körben alkalmazzák sajtokban, joghurtokban, gyümölcslevekben, borokban és péksüteményekben. A szorbinsav és sói a gombasejtek enzimeit gátolják, különösen savas pH-n hatékonyak.
- Benzoátok (pl. nátrium-benzoát): Gyakran használják savas élelmiszerekben és italokban, mint például üdítőitalok, gyümölcslevek, salátaöntetek és savanyúságok. A benzoátok a gombasejtek membránfunkcióját zavarják meg, gátolva a tápanyagfelvételt.
- Parahidroxi-benzoesav és észterei (parabének): Bár vitatott a használatuk, kozmetikumokban és egyes élelmiszerekben, például sörben és húsipari termékekben alkalmazzák őket fungisztatikus hatásuk miatt.
Ezek a szerek általában kis koncentrációban hatásosak, és az élelmiszerbiztonsági előírások szigorúan szabályozzák a megengedett maximális mennyiségüket. A cél az, hogy hatékonyan gátolják a gombák növekedését anélkül, hogy káros hatással lennének a fogyasztóra vagy az élelmiszer érzékszervi tulajdonságaira.
Hatásmechanizmusok és szabályozás
A legtöbb élelmiszeripari fungisztatikus szer a gombasejt számos alapvető folyamatába beavatkozik, például a membrán permeabilitásába, az enzimatikus aktivitásba vagy az energiatermelésbe. A savas tartósítószerek, mint a szorbinsav és a benzoesav, különösen hatékonyak alacsony pH-értéken, mivel protonált formájukban könnyebben bejutnak a gombasejtbe, ahol felborítják a belső pH-egyensúlyt és gátolják az enzimeket.
Az élelmiszeripari fungisztatikus szerek alkalmazásának szabályozása rendkívül szigorú. Az Európai Unióban és más országokban is részletes jogszabályok határozzák meg, hogy mely anyagok használhatók, milyen élelmiszerekben és milyen maximális mennyiségben. Ezek a szabályozások a fogyasztók egészségének védelmét szolgálják, és biztosítják, hogy az élelmiszerek biztonságosak legyenek a fogyasztásra.
A tartósítószerek mellett az élelmiszeripar más módszereket is alkalmaz a gombák elleni védekezésre, például a hűtést, fagyasztást, szárítást, pasztőrözést, vagy a módosított atmoszférájú csomagolást. A fungisztatikus szerek ezekkel a fizikai módszerekkel kombinálva maximalizálják az élelmiszerek eltarthatóságát és minimalizálják a romlás kockázatát.
Az élelmiszeripari fungisztatikus szerek hozzájárulnak a élelmiszer-pazarlás csökkentéséhez, a termékek hosszabb ideig történő tárolásához és szállításához, ezáltal növelve az élelmiszer-ellátás biztonságát és gazdaságosságát.
Fungisztatikus szerek a mikrobiológiai kutatásban és laboratóriumi diagnosztikában

A mikrobiológiai kutatásban és a laboratóriumi diagnosztikában a fungisztatikus szerek elengedhetetlen eszközök a gombák tanulmányozásához, azonosításához és az ellenük irányuló terápiák fejlesztéséhez. Ezek az anyagok lehetővé teszik a kutatók számára, hogy kontrollált körülmények között vizsgálják a gombák növekedését, metabolizmusát és gyógyszerérzékenységét.
Az egyik legfontosabb alkalmazási terület a szelektív táptalajok előállítása. Bizonyos fungisztatikus szereket, például cikloheximidet vagy klóramfenikolt, hozzáadnak a táptalajokhoz, hogy gátolják a nem kívánt gombák vagy baktériumok növekedését, miközben lehetővé teszik a célzott mikroorganizmusok izolálását és azonosítását. Például a Sabouraud dextróz agar cikloheximiddel kiegészítve szelektíven gátolja a gyorsan növő szennyező gombákat, elősegítve a patogén gombák izolálását.
A gombaellenes érzékenységi vizsgálatok (antifungal susceptibility testing, AFST) szintén alapvető fontosságúak. Ezek a tesztek meghatározzák, hogy egy adott gombatörzs mennyire érzékeny a különböző gombaellenes szerekre. A mikrohígításos módszer, az agar-diffúziós tesztek (pl. E-teszt) és a diszkdiffúziós módszer mind fungisztatikus szerekkel végzett vizsgálatokra épülnek, ahol a legkisebb gátló koncentrációt (MIC) határozzák meg. Az MIC az a legalacsonyabb szerkoncentráció, amely láthatóan gátolja a gomba növekedését.
Ezek az információk kritikusak a klinikai döntéshozatalban, mivel segítenek az orvosoknak kiválasztani a leghatékonyabb gombaellenes terápiát a beteg számára. A laboratóriumok rendszeresen végzik ezeket a teszteket, különösen súlyos vagy rezisztens fertőzések esetén, hogy optimalizálják a kezelési stratégiákat.
Kutatási eszközök és új gyógyszerek fejlesztése
A fungisztatikus szerek a gyógyszerkutatásban is nélkülözhetetlenek. Új gombaellenes vegyületek szűrésekor és fejlesztésekor a fungisztatikus hatás az elsődleges szempontok egyike. A kutatók nagy áteresztőképességű szűrési módszereket (high-throughput screening) alkalmaznak, amelyek során több ezer vegyületet vizsgálnak meg fungisztatikus aktivitásuk szempontjából gombakultúrákon.
Ezek a szerek segítenek megérteni a gombák biokémiai útvonalait és a gyógyszerrezisztencia mechanizmusait. A különböző fungisztatikus szerekkel végzett kísérletek révén a kutatók azonosíthatják a gombasejt új, potenciális gyógyszercélpontjait, ami alapvető fontosságú az új generációs gombaellenes szerek kifejlesztéséhez.
A biofilm-kutatásban is alkalmaznak fungisztatikus szereket. A gombák gyakran biofilmeket képeznek, amelyek rendkívül rezisztensek a hagyományos gombaellenes terápiákkal szemben. A fungisztatikus szerek hatását vizsgálják a biofilm képződésére és a már kialakult biofilmekre, hogy hatékonyabb stratégiákat dolgozzanak ki ezen komplex fertőzések kezelésére.
Összességében a fungisztatikus szerek alapvető eszközök a mikrobiológiai laboratóriumokban, lehetővé téve a gombák pontos diagnosztizálását, a gyógyszerérzékenység meghatározását és az új gombaellenes terápiák felfedezését és fejlesztését. A folyamatos kutatás és fejlesztés ezen a területen kulcsfontosságú a növekvő gombaellenes rezisztencia kihívásainak leküzdéséhez.
Rezistencia kialakulása és kezelése a fungisztatikus terápiák során
A gombaellenes rezisztencia az egyik legnagyobb kihívás a fungisztatikus terápiák hatékonysága szempontjából, mind a humán, mind az állatgyógyászatban, mind pedig a növényvédelemben. Ahogy a baktériumok esetében, a gombák is képesek genetikai mutációk vagy génátvitel révén ellenállóvá válni a gyógyszerekkel szemben, ami a kezelés kudarcához vezethet.
A rezisztencia kialakulása különösen aggasztó a fungisztatikus szerek esetében, mivel ezek nem pusztítják el a gombákat, csupán gátolják azok növekedését. Ez azt jelenti, hogy a gombák hosszabb ideig vannak kitéve a szer hatásának, ami nagyobb szelekciós nyomást gyakorol rájuk, elősegítve a rezisztens törzsek elszaporodását. A nem megfelelő adagolás, a túl rövid kezelési idő vagy a gyógyszeres terápia idő előtti abbahagyása mind hozzájárulhat a rezisztencia kialakulásához.
Főbb rezisztencia mechanizmusok:
- Célpont módosulása: A gomba megváltoztatja azt a molekuláris célpontot, amelyre a szer hat, így az már nem tud hatékonyan kötődni. Például az azolokkal szembeni rezisztencia gyakran az ergosterol bioszintézisében részt vevő CYP51 enzim mutációjából ered.
- Efflux pumpák fokozott aktivitása: A gombasejtek olyan pumpafehérjéket termelnek, amelyek aktívan kipumpálják a gombaellenes szert a sejtből, mielőtt az elérné a célpontját. Ez a mechanizmus gyakori az azolokkal és echinocandinokkal szembeni rezisztenciában.
- Célpont túlzott termelése: A gomba fokozott mennyiségben termeli a gyógyszer célpontját, így a szer koncentrációja nem elegendő az összes célpont gátlásához.
- Alternatív metabolikus útvonalak: A gomba képes alternatív útvonalakat használni a létfontosságú vegyületek szintézisére, megkerülve a gyógyszer által gátolt folyamatot.
- Biofilm képződés: A biofilmekben élő gombák mechanikusan védettek a gombaellenes szerekkel szemben, és a biofilmben lévő sejtek metabolikus állapota is eltérő lehet, ami csökkenti a gyógyszerek hatékonyságát.
A rezisztencia kezelésének stratégiái:
A rezisztencia elleni küzdelem komplex megközelítést igényel, amely magában foglalja a megelőzést, a korai felismerést és az optimalizált terápiás stratégiákat.
1. Kombinált terápia: Két vagy több, eltérő hatásmechanizmusú fungisztatikus vagy fungicid szer együttes alkalmazása csökkentheti a rezisztencia kialakulásának esélyét, mivel a gombának egyszerre több mechanizmust kellene kifejlesztenie az ellenálláshoz. Például a flucytozin és az amphotericin B kombinációja.
2. Új gyógyszerek fejlesztése: Folyamatos kutatásra és fejlesztésre van szükség új hatásmechanizmusú gombaellenes szerek azonosítására. Ez magában foglalhatja új célpontok felfedezését vagy a meglévő szerek módosítását a rezisztencia leküzdése érdekében.
3. Prudens gyógyszerhasználat: Az indokolatlan vagy helytelen gombaellenes szerhasználat minimalizálása kulcsfontosságú. Ez magában foglalja a pontos diagnózist, a megfelelő szer kiválasztását, a helyes adagolást és a teljes kezelési időtartam betartását.
4. Gombaellenes érzékenységi tesztelés: Rendszeres AFST elvégzése, különösen krónikus vagy kiújuló fertőzések esetén, segíthet azonosítani a rezisztens törzseket és irányt mutatni a megfelelő terápia kiválasztásához.
5. Felügyelet és epidemiológia: A gombaellenes rezisztencia mintázatainak folyamatos monitorozása és a járványügyi adatok gyűjtése elengedhetetlen a rezisztens törzsek terjedésének nyomon követéséhez és a közegészségügyi beavatkozások megtervezéséhez.
A gombaellenes rezisztencia egy dinamikusan változó probléma, amely állandó éberséget és adaptív stratégiákat igényel a hatékony kezelés és a közegészségügy védelme érdekében.
A jövő kihívásai és lehetőségei a fungisztatikus szerek fejlesztésében
A fungisztatikus szerek fejlesztése folyamatos kihívásokkal és ígéretes lehetőségekkel néz szembe. A gombás fertőzések növekvő gyakorisága, különösen az immunhiányos populációkban, valamint a gombaellenes rezisztencia terjedése sürgőssé teszi az új, hatékonyabb és biztonságosabb terápiák kidolgozását.
Az egyik fő kihívás az új gyógyszercélpontok azonosítása. Mivel a gombák eukarióta szervezetek, sok alapvető biológiai folyamatuk hasonló a humán gazdaszervezet folyamataihoz, ami korlátozza a szelektíven toxikus szerek fejlesztési lehetőségeit. A kutatók ezért olyan egyedi gomba-specifikus útvonalakat és struktúrákat keresnek, amelyek minimális mellékhatással gátolhatók.
Ilyen potenciális új célpontok lehetnek a gombákban található virulencia faktorok, például a tapadást, inváziót vagy immunmodulációt segítő fehérjék. Az ezen faktorokat gátló szerek nem feltétlenül pusztítják el a gombát, de csökkenthetik annak patogenitását, lehetővé téve a gazdaszervezet immunrendszerének hatékonyabb fellépését.
A kvórumérzékelés (quorum sensing) gátlása is egy ígéretes stratégia. A gombák, különösen a Candida albicans, kvórumérzékelő molekulákat használnak a populáció sűrűségének érzékelésére és a virulenciafaktorok, például a biofilm képződésének szabályozására. Az ezeket a jelzőutakat gátló vegyületek megakadályozhatják a gombák patogén formává alakulását vagy a biofilm kialakulását.
Innovatív megközelítések és technológiák
Az új gyógyszerkifejlesztési módszerek, mint például a strukturális biológia és a számítógépes gyógyszertervezés, felgyorsíthatják az új fungisztatikus vegyületek felfedezését. Ezek a technikák lehetővé teszik a gyógyszercélpontok részletes molekuláris szintű elemzését, és a potenciális hatóanyagok racionális tervezését.
A nanotechnológia szintén új lehetőségeket kínál. A gyógyszerek nanorészecskékbe vagy liposzómákba történő bejuttatása javíthatja a szerek oldhatóságát, stabilitását, célzott szállítását és csökkentheti a toxicitásukat. Ez különösen hasznos lehet a nehezen hozzáférhető fertőzések, például a központi idegrendszer gombás megbetegedéseinek kezelésében.
A kombinált terápiák optimalizálása továbbra is kulcsfontosságú. Az egymást szinergikusan erősítő szerek azonosítása, amelyek eltérő hatásmechanizmusokkal rendelkeznek, segíthet a rezisztencia leküzdésében és a terápia hatékonyságának növelésében. A gyógyszer-gyógyszer interakciók és a mellékhatások minimalizálása azonban továbbra is fontos szempont.
A biopesticidek és biológiai védekezési ágensek fejlesztése a mezőgazdaságban egyre nagyobb hangsúlyt kap. A természetes eredetű fungisztatikus vegyületek, például növényi kivonatok vagy mikroorganizmusok által termelt anyagok, környezetbarát alternatívát kínálhatnak a szintetikus fungicidekkel szemben.
Végül, a személyre szabott orvoslás elveinek alkalmazása a fungisztatikus terápiákban is egyre inkább előtérbe kerül. A beteg genetikai profiljának, az immunválaszának és a fertőző gomba genotípusának figyelembevételével optimalizálni lehet a kezelést, növelve a hatékonyságot és csökkentve a mellékhatásokat.










